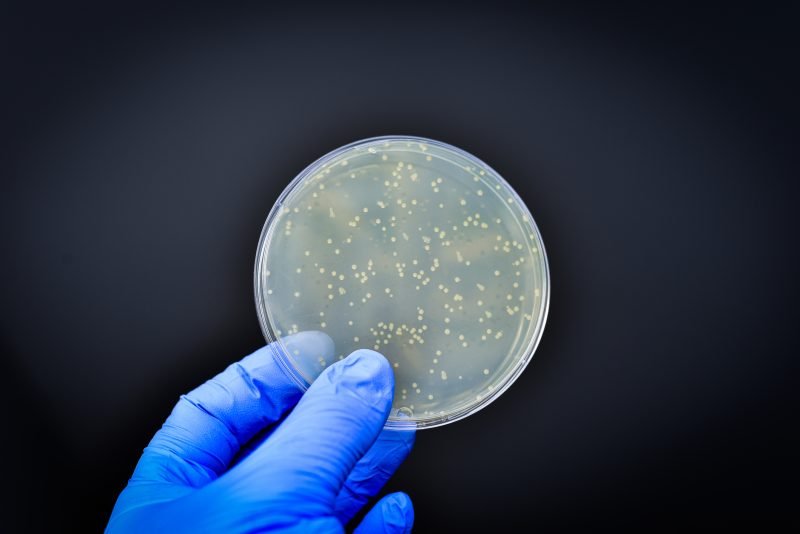
Más del 70% de genes de resistencia a antibióticos están en la cadena alimentaria

Simulacro durante la capacitación. (Fuente: CEDIMAT)
EL NUEVO DIARIO, SANTO DOMINGO.- Especialistas de los Centros de Diagnóstico y Medicina Avanzada y de Conferencias Médicas y Telemedicina (CEDIMAT) revelaron este domingo que apenas el 12 % de los pacientes que sufren un accidente cerebrovascular (ACV) en República Dominicana, logran llegar a tiempo a una emergencia para recibir un tratamiento efectivo.
CEDIMAT explicó en ese sentido, que la identificación tardía de los síntomas sigue siendo uno de los principales desafíos. Ante esto, informó que ha iniciado una serie de capacitaciones dirigidas al personal médico prehospitalario con el objetivo de mejorar significativamente la respuesta ante estas emergencias.
«Esta capacitación representa un paso firme hacia la mejora de los tiempos de respuesta y la reducción de las secuelas discapacitantes que estos eventos pueden provocar», dijo.
En una nota de prensa CEDIMAT explicó que la más reciente jornada formativa fue dirigida al equipo de PROMED Dominicana, empresa especializada en servicios de ambulancia, como parte del convenio estratégico suscrito entre CEDIMAT y el Grupo Read. 
Durante la capacitación, médicos especialistas abordaron temas vitales como la activación del Código ACV desde la ambulancia, los pasos clave durante los primeros 30 minutos tras la llegada del paciente a emergencia y la correcta coordinación para su traslado a un centro adecuado. La doctora Edwina Luna, coordinadora de la Unidad de ACV, subrayó que CEDIMAT es el primer hospital en Santo Domingo certificado internacionalmente como Centro de Manejo Avanzado de ACV por la World Stroke Organization y la Sociedad Iberoamericana de Enfermedad Cerebrovascular.

“Actuar con rapidez lo cambia todo” coincidieron los expertos, que reiteraron que cada minuto perdido durante un ACV implica la muerte de millones de neuronas. La educación del personal de primera respuesta y la concienciación ciudadana son claves para aumentar el porcentaje de pacientes que llegan a tiempo y reducir las secuelas discapacitantes que estos eventos provocan.
Además del ACV, el acuerdo entre las instituciones contempla la homologación de protocolos de atención ante infartos agudos al miocardio, apuntando a consolidar una red nacional de respuesta médica rápida y especializada.